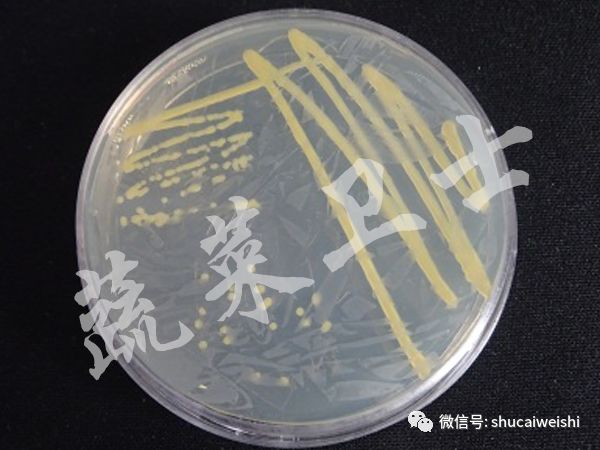
辣椒苗期病毒病的防治,辣椒蓟马花叶病

一、辣椒疮痂病严重,如何急救?
近日,辽宁省、河北省和河南省等地的辣椒种植户向我们紧急求助,他们发现辣椒叶片上长有大量暗褐色不规则病斑,这严重影响辣椒的产量及农户的经济收益。我们通过实验室镜检及分离培养等手段,结合田间发病症状,确定该病为辣椒细菌性疮痂病,并针对该病提出有效的防控措施。
1、发病症状及病原菌诊断
(1)田间症状
辣椒细菌性疮痂病又称辣椒细菌性斑点病,俗称“疱病”,该病可以发生在叶片、果实及茎秆上,其中以叶片发生普遍。在叶片上一般表现出褐色不规则形病斑,病斑边缘隆起,连在一起,病斑周围大片呈黄褐色,或者沿着叶缘发病,在叶片边缘呈黄褐色和暗褐色的连片病斑;茎秆发病初生水渍状不规则的条斑,后木栓化隆起,纵裂呈溃疡状疮痂斑;果实上初生黑色或褐色隆起的小点,或为一种具有狭窄水渍状边缘的泡疹,逐渐扩大,成为隆起的圆形或长圆形的黑色疮痂斑。



图1 不同地区的辣椒细菌性疮痂病田间发病症状
(2)病原菌
我们提取病样的DNA,利用特异性引物XCVF\XCVR进行分子检测(如图2)并结合田间症状,我们可以确认其为辣椒细菌性疮痂病,其病原为野油菜黄单胞辣椒斑点致病变种(Xanthomonas campestris pv. vesicatoria (Doidge) Dye),该病原菌为直杆菌,革兰氏染色为阴性。在 NA 培养基上培养 3 天后,呈淡黄色圆形菌落,粘稠状,边缘整齐,表面隆起,有光泽(如图3)。

图2 辣椒细菌性疮痂病PCR电泳图
(M: BM5000 DNA Marker;1、病样1;2、病样2;3、病样;4、病样4;5、病样5;6、病样6;7、阳性对照;8、阴性对照)
图3 NA培养基上菌落形态
2、辣椒疮痂病为何能够大面积发生?
(1)种子带菌
辣椒细菌性疮痂病是种传病害,种子带菌率很高。病原菌主要在种子表面越冬,成为翌年病害发生的初侵染源,同时也可以借带菌种子作远距离传播。
(2)苗木及病残体传播
在田间,只要有10%的植株发病,就为整块田发病提供了足够的菌量。并且,病原菌可以随病株残体在田间越冬,将感病植株放置到田间,6个月后仍能检测到该病原菌。
(3)杂草、土壤传播
辣椒细菌性疮痂病菌也可以在杂草、土壤中越冬。当病原菌积累足够的量并且温度、湿度等条件适宜时,便开始侵染,并逐渐扩大。
(4)雨水、露水及灌溉水传播
雨后,植株伤口增加,细菌菌体随着雨水飞溅传播到其他叶片,可能是通过气孔侵入,也可能随着雨水和灌溉水的流动在田间传播。另外,在大雾结露的情况下,空气湿度足够大,也为病原菌的传播提供了良好的外部环境。
(5)农事操作传播
种植过密,生长过旺,农事操作时易造成植株间叶片的频繁接触摩擦而产生伤口,增加了病原菌的侵染机会。除此之外,农事操作人员在发病田块活动携带病菌后,也能传播到本田块或其他田块。
3、辣椒细菌性疮痂病的防治技术
辣椒细菌性疮痂病传播很快,前期预防工作尤为重要,在发病前和发病初期施药,能有效地预防和控制病菌的发生和传播。
(1)种子检测及消毒技术
辣椒细菌性疮痂病是种传病害,种子带菌率很高。对种子进行带菌检测,可以应用 PCR 技术来定性和定量地检测种子上的细菌,确定种子的健康状况。同时还要做好种子消毒工作,用3%中生菌素可湿性粉剂1000倍液或1.05%的次氯酸钠溶液浸种30分钟,取出冷水冲洗后催芽播种,可以有效地消除种子表面携带的病原菌。
(2)田间管理措施
①土壤消毒
使用石灰氮对土壤进行消毒,覆盖地膜,结合高温闷棚,杀死土壤中的部分病原菌。若发现病株和杂草应及时清除并烧毁,避免雨水和灌溉水冲刷后的再次污染。
②高畦栽培
采取高畦栽培、膜下灌水等方法,避免辣椒底部叶片与水直接接触,减少雨水或灌溉水飞溅的传播。雨季关注排水,防止积水,尤其在露地栽培时,在有条件的情况下,进行避雨栽培,如搭建避雨棚。
③合理密植,规范农事操作
种植密度要合适,及时整枝,避免种植过密及生长过旺使枝条和叶片频繁摩擦产生物理伤口,防止细菌通过伤口传播。大雨过后和大雾结露时避免进行农事操作,防止病菌在高温高湿的环境中快速繁殖和传播或等农田露水下去后再进行农事操作,操作完毕后对农事操作人员的衣服、鞋子和农具等进行清洗后,可用75%的酒精消毒,防止将病原菌带入健康田块。
(3)科学使用药剂,安全有效防控
合理使用药剂能有效地防治辣椒细菌性疮痂病。如用 72 % 农用链霉素可湿性粉剂4000倍液或 3 %中生菌素可湿性粉剂500倍液进行喷雾,隔7天喷1次,连续喷 2~3 次;在病害发生前期或初期用50%春雷王铜可湿性粉剂1200倍液喷雾,视病害发生情况,每隔7-10天施药1次。关注,铜制剂应与其他试剂轮换使用,避免产生抗药性,可达更好的防治效果。
作者:李晓菁 常群 中国农业科学院蔬菜花卉研究所
由国家重点研发计划“露地蔬菜化肥农药减施技术集成研究与示范(2018YFD201200)”项目提供技术支持
二、蓟马难防,我有妙招!
夏季是茄子上蓟马为害的高峰季节,一旦发生蓟马是一件麻烦事,防治费时费力还效果不好,甚至出现越治越重的情况。近期有群友反应茄子果实上有疤痕,形成条状木栓化黄斑,这是蓟马危害的典型症状,需要我们准确识别并采取有效措施进行防治是至关重要的。


蓟马喜温暖干燥的环境, 所以为了有效的预防蓟马的发生,首先可以通过合理的水肥管理,小水勤浇,避免产生干旱的环境,及时清除田间杂草。其次,可以利用蓟马对蓝色的强趋性,在田间悬挂蓝板,起到监测和诱杀的作用。最后,关注合理用药防治,苗期可采用噻虫嗪进行喷淋和灌根,蓟马发生初期可采用吡虫啉、乙基多杀菌素、啶虫脒进行喷雾防治,值得关注的是蓟马怕强光,可选择在傍晚进行喷药防治,喷药时重点喷施植株幼嫩组织如花、幼果、叶背等,要做到全面细致,地面也要喷施,同时要关注药剂的交替使用,延缓抗药性的产生。
三、高温季,谨防茄果类蔬菜脐腐病发生
脐腐病是茄果类蔬菜生产中一种常见的生理性病害,直接影响茄果类的产量和品质。辣椒脐腐病多发生于幼果脐部,发病初期,脐部会出现圆形或不规则水渍状、暗绿色病斑,后逐渐变为暗褐或黑色,后期脐部干缩、表面凹陷,在潮湿环境下,还会产生黑色或粉红色霉状物,需要引起大家的高度重视!

脐腐病一般是由果实缺钙引起的,夏季发病严重的原因还与水分胁迫、温度高、施肥不合理等原因有关。
为了能够有效的预防脐腐病的发生,首先要合理施肥,基肥注重有机肥和钙肥的施用,果实膨大期要合理施肥,关注增施钙肥,避免氮肥施用过多,加强水分管理,保证水均匀供应,田间浇水宜在早晨或傍晚进行,关注做到勤浇、浅浇,再浇水时可随水冲施复合甲壳素有机水溶肥、海藻酸等,培育健壮植株。其次,加强温度管理,可通过悬挂遮阳网、喷洒降温剂、泼洒泥浆、小水勤浇等方式来降低棚内温度。最后,进入结果盛期,对硼钙的需要明显增多,可从初花期开始,喷洒硝酸钙+硼砂进行补充钙、硼元素。
四、*粉白**病频发原因到底是为何?
夏季高温、闷湿天气使得瓜类*粉白**病发生严重,施肥不当、植株徒长、通风不良等原因都会造成该病的发生。近期,多地群友反应*粉白**病发生严重,且蔓延速度很快。

从图片中我们可以清楚的看到叶面出现白色近圆形星状小粉斑,这是*粉白**病的典型症状,需要准确识别并提前预防!
*粉白**病在忽干忽湿环境条件下发生严重,为了有效预防*粉白**病的发生,首先要选用抗病品种,在播种或定植前,可用百菌清熏棚,可有效去除棚室内病原菌。其次,加强田间管理,发现病叶及时摘除,关注通风透光,合理施肥,培育健壮植株,有条件的地方实行滴灌,防止棚内忽然湿度过高,最后,在发病初期及时用药,可选用醚菌酯、苯醚甲环唑、氟唑活化脂等药剂进行喷雾防治。
作者:菜豆